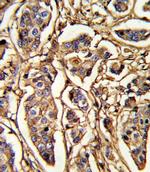
Thrombospondin 1 Antibody in Immunohistochemistry (Paraffin) (IHC (P))

Search
Invitrogen
Thrombospondin 1 Polyclonal Antibody
{{$productOrderCtrl.translations['antibody.pdp.commerceCard.promotion.promotions']}}
{{$productOrderCtrl.translations['antibody.pdp.commerceCard.promotion.viewpromo']}}
{{$productOrderCtrl.translations['antibody.pdp.commerceCard.promotion.promocode']}}: {{promo.promoCode}} {{promo.promoTitle}} {{promo.promoDescription}}. {{$productOrderCtrl.translations['antibody.pdp.commerceCard.promotion.learnmore']}}
图: 1 / 4
Thrombospondin 1 Antibody (PA5-35334) in ICC/IF

产品信息
PA5-35334
宿主/亚型
分类
类型
抗原
偶联物
形式
浓度
保存条件
运输条件
RRID
产品详细信息
This antibody is predicted to react with bovine based on sequence homology.
靶标信息
Thrombospondin is a protein from platelet a-granules. It is made up of three identical subunits bound by interchain disulfides. It is secreted at sites of platelet activation and aggregation and is involved in the processes of chemotaxis, adhesion, proliferation and differentiation of leukocytes, fibroblasts, smooth muscle and endothelial cells.
仅用于科研。不用于诊断过程。未经明确授权不得转售。



